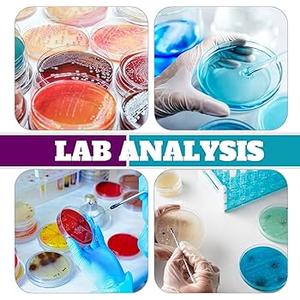
Ashmacdo 60 Pcs Plastic Petri Dishes with Lids, 90 x 15 mm Deep Sterile Petri Dishes with 60Pcs Biohazard Stickers for School Halloween Science Experiment Biological Party Supplies

10 Pack Sterile Thick Plastic Petri Dishes with Lid, 90mm Dia x 15mm Deep Clear 3 Vents Petri Dish for Lab Science Experiment (90mm - No Agar)
Condition: Appears New
Pickup Details
| Tuesday, Apr 7 | 11:00AM - 06:00PM (Appointment only) |
| Wednesday, Apr 8 | 11:00AM - 06:00PM (Appointment only) |
| Thursday, Apr 9 | 11:00AM - 06:00PM |
| Friday, Apr 10 | 11:00AM - 06:00PM (Appointment only) |
Product Details
| SKU | OLARR7156990 |
| ASIN | B09VK7N1JV |